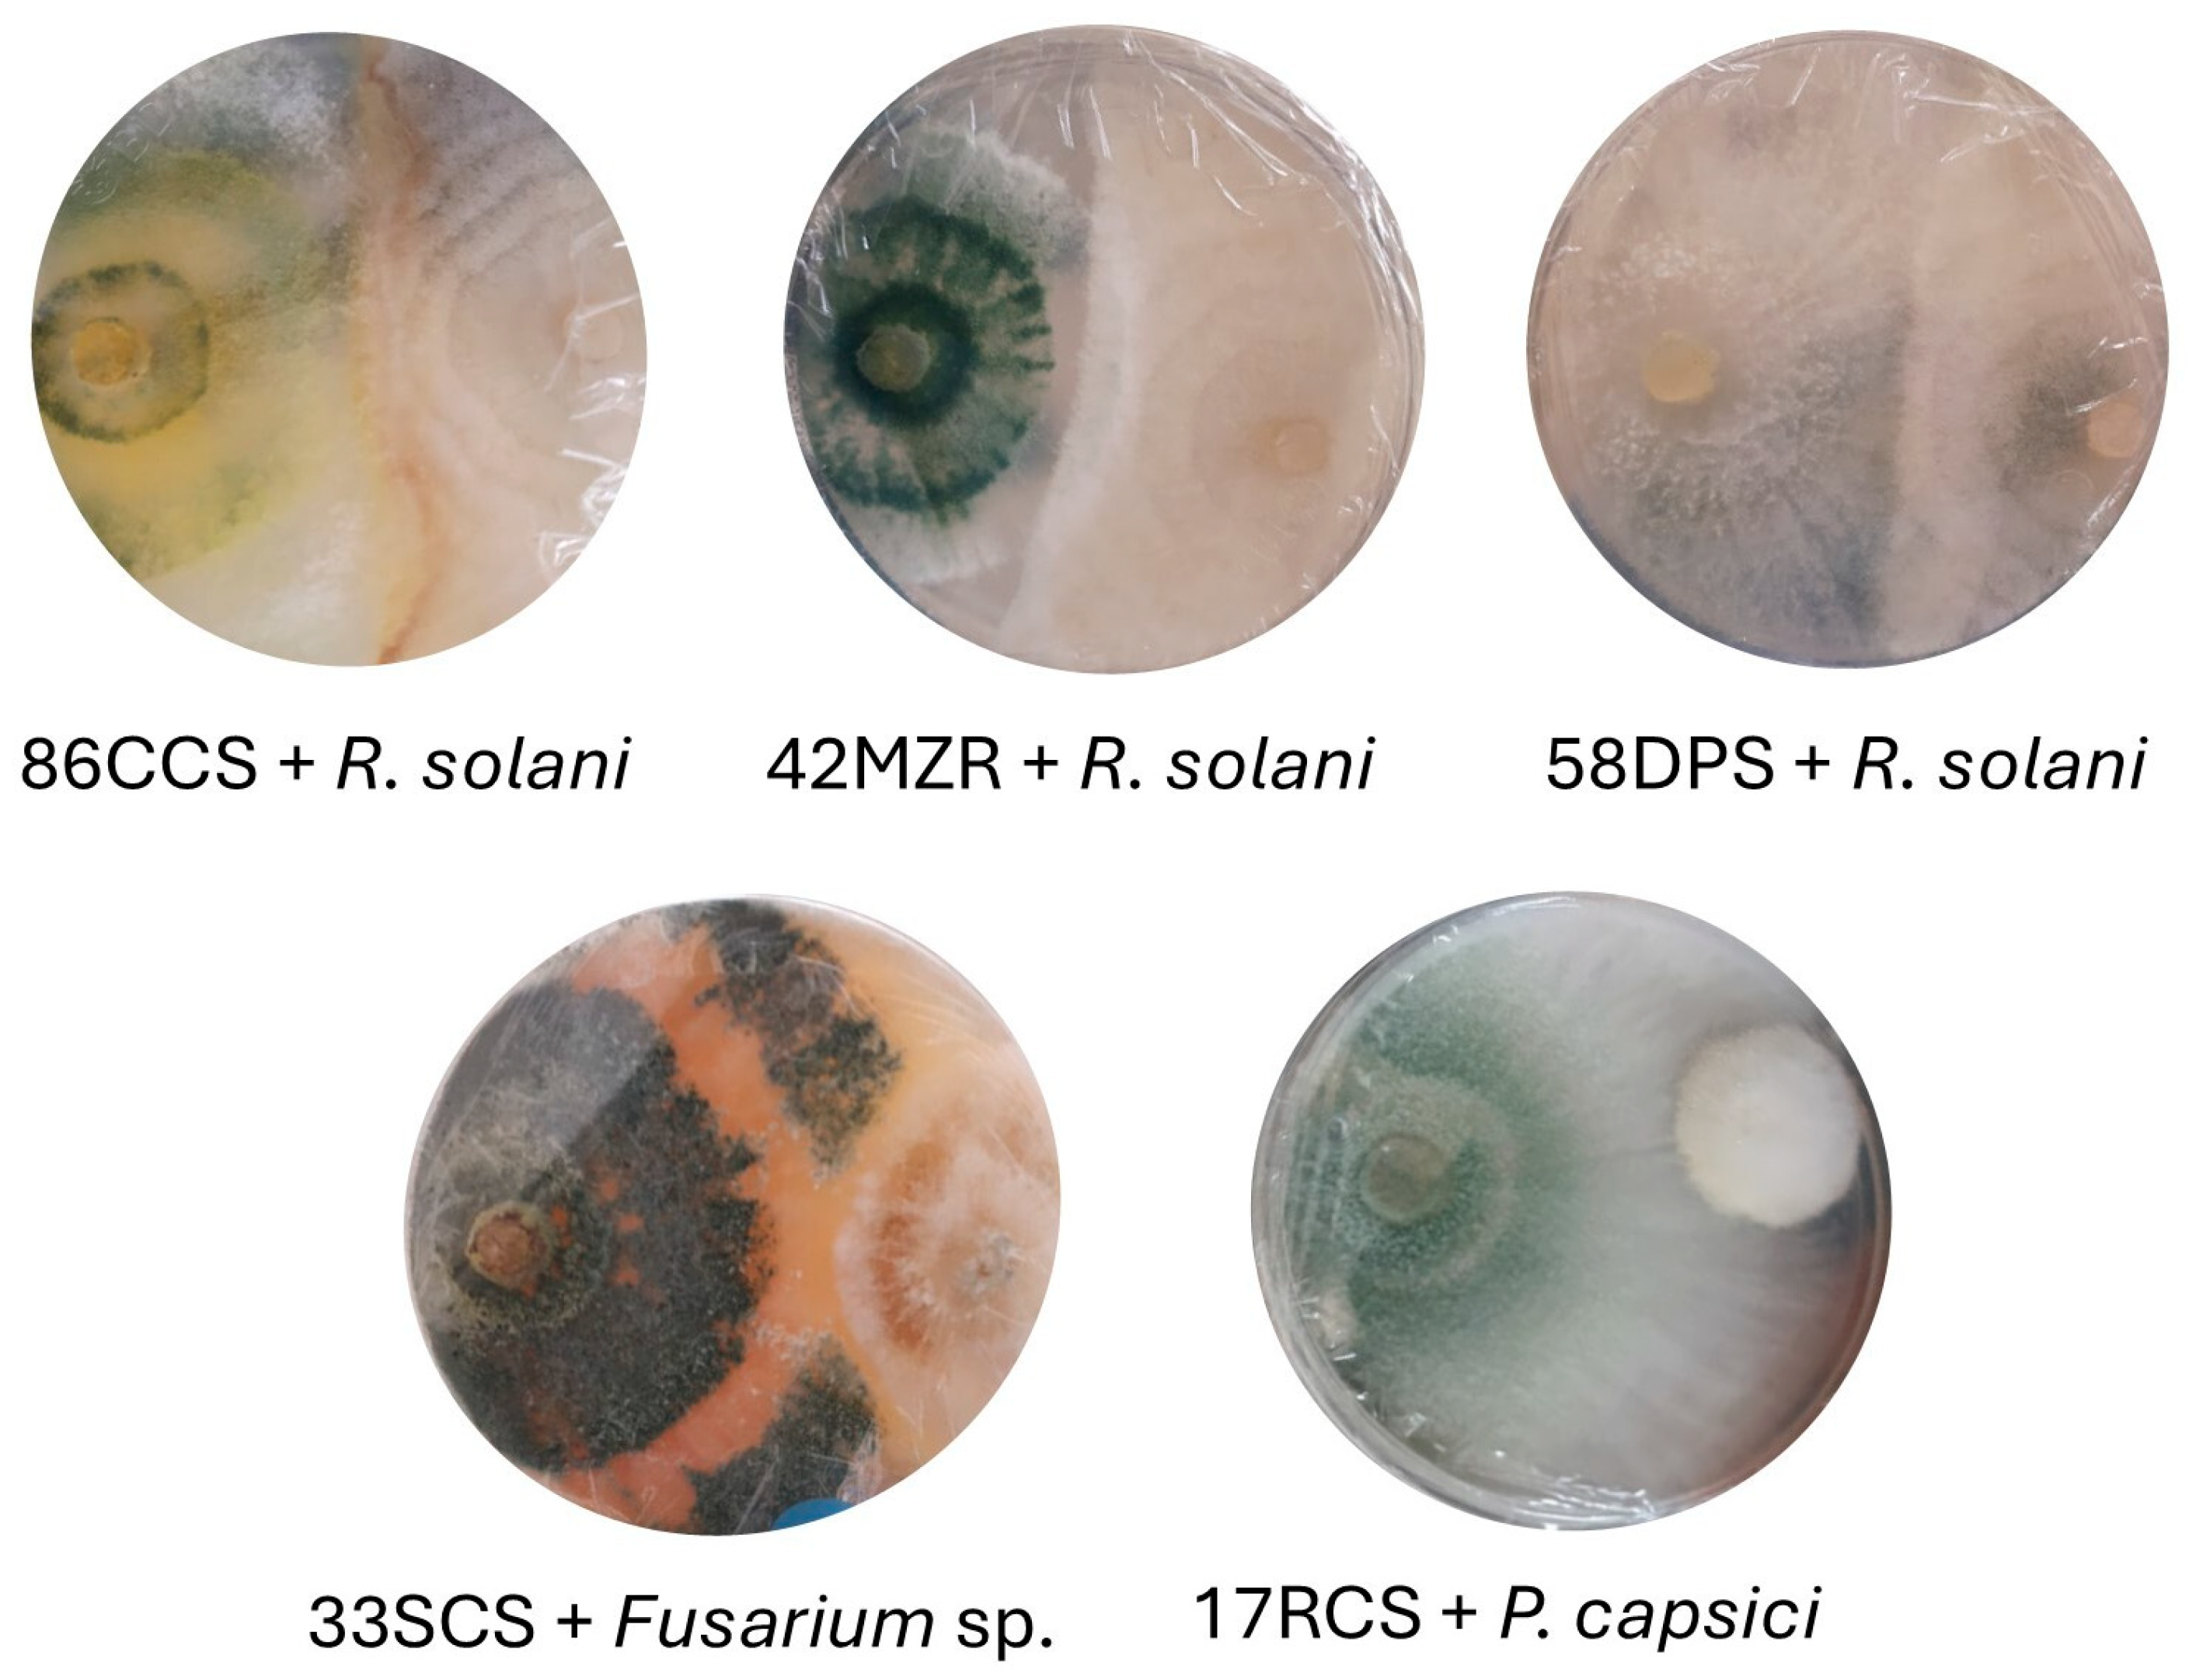
Jof 11 00174 g004

Trichoderma Species from Semiarid Regions and Their Antagonism Against the Microorganisms That Cause Pepper Wilt
Abstract
1. Introduction
2. Materials and Methods
2.1. Sampling
2.2. Isolation and Morphological Identification of Trichoderma spp.
2.3. Molecular Identification
2.4. Phylogenetic Analysis
2.5. Isolation and Identification of Phytopathogenic Fungi
2.6. Antagonism Tests In Vitro
2.6.1. Dual-Culture Test
2.6.2. Volatile Organic Compound Activity
2.6.3. Non-Volatile Organic Compound Activity
2.7. Experiment Design and Statistical Analysis
3. Results
3.1. Isolation and Morphological Identification of Trichoderma spp.
3.2. Isolation and Morphological Identification of Phytopathogenic Microorganism
3.3. Phylogenetic Analysis
3.4. Evaluation of Antagonism of Trichoderma spp. Against Phytopathogenic Microorganisms
3.4.1. Dual-Culture Test
3.4.2. Non-Volatile Organic Compound Activity
3.4.3. Volatile Organic Compounds
4. Discussion
5. Conclusions
Supplementary Materials
Author Contributions
Funding
Institutional Review Board Statement
Informed Consent Statement
Data Availability Statement
Acknowledgments
Conflicts of Interest
References
- Pérez-Acevedo, C.E.; Carrillo-Rodríguez, J.C.; Chávez-Servia, J.L.; Perales-Segovia, C.; Enríquez del Valle, R.; Villegas-Aparicio, Y. Diagnóstico de síntomas y patógenos asociados con marchitez del chile en Valles Centrales de Oaxaca. Rev. Mex. Cienc. Agríc. 2017, 8, 281–293. [Google Scholar]
- Tomah, A.A.; Abd Alamer, I.S.; Li, B.; Zhang, J.-Z. A new species of Trichoderma and gliotoxin role: A new observation in enhancing biocontrol potential of T. virens against Phytophthora capsici on chili pepper. Biol. Control 2020, 145, 104261. [Google Scholar] [CrossRef]
- Delai, C.; Muhae-Ud-Din, G.; Abid, R.; Tian, T.; Liu, R.; Xiong, Y.; Ma, S.; Ghorbani, A. A comprehensive review of integrated management strategies for damping-off disease in chili. Front. Microbiol. 2024, 15, 1479957. [Google Scholar] [CrossRef] [PubMed]
- Andrade-Hoyos, P.; Luna-Cruz, A.; Osorio-Hernández, E.; Molina-Gayosso, E.; Landero-Valenzuela, N.; Barrales-Cureño, H.J. Antagonismo de Trichoderma spp. vs hongos asociados a la marchitez de chile. Rev. Mex. Cienc. Agríc. 2019, 10, 1259–1272. [Google Scholar] [CrossRef]
- Sood, M.; Kapoor, D.; Kumar, V.; Sheteiwy, M.S.; Ramakrishnan, M.; Landi, M.; Araniti, F.; Sharma, A. Trichoderma: The “secrets” of a multitalented biocontrol agent. Plants 2020, 9, 762. [Google Scholar] [CrossRef]
- Köhl, J.; Kolnaar, R.; Ravensberg, W.J. Mode of action of microbial biological control agents against plant diseases: Relevance beyond efficacy. Front. Plant Sci. 2019, 10, 845. [Google Scholar] [CrossRef]
- Vinale, F.; Sivasithamparam, K.; Ghisalberti, E.L.; Marra, R.; Woo, S.L.; Lorito, M. Trichoderma–plant–pathogen interactions. Soil Biol. Biochem. 2008, 40, 1–10. [Google Scholar] [CrossRef]
- Contreras-Cornejo, H.A.; Macías-Rodríguez, L.; Del-Val, E.; Larsen, J. Ecological functions of Trichoderma spp. and their secondary metabolites in the rhizosphere: Interactions with plants. FEMS Microbiol. Ecol. 2016, 92, fiw036. [Google Scholar] [CrossRef]
- Kredics, L.; Hatvani, L.; Naeimi, S.; Körmöczi, P.; Manczinger, L.; Vágvölgyi, C.; Druzhinina, I. Biodiversity of the genus Hypocrea/Trichoderma in different habitats. In Biotechnology and Biology of Trichoderma; Elsevier: Amsterdam, The Netherlands, 2014; pp. 3–24. [Google Scholar]
- Guzmán-Guzmán, P.; Porras-Troncoso, M.D.; Olmedo-Monfil, V.; Herrera-Estrella, A. Trichoderma species: Versatile plant symbionts. Phytopathology 2019, 109, 6–16. [Google Scholar] [CrossRef]
- Saravanakumar, K.; Yu, C.; Dou, K.; Wang, M.; Li, Y.; Chen, J. Synergistic effect of Trichoderma-derived antifungal metabolites and cell wall degrading enzymes on enhanced biocontrol of Fusarium oxysporum f. sp. cucumerinum. Biol. Control 2016, 94, 37–46. [Google Scholar] [CrossRef]
- Schuster, A.; Schmoll, M. Biology and biotechnology of Trichoderma. Appl. Microbiol. Biotechnol. 2010, 87, 787–799. [Google Scholar] [CrossRef] [PubMed]
- Cabral-Miramontes, J.P.; Olmedo-Monfil, V.; Lara-Banda, M.; Zúñiga-Romo, E.R.; Aréchiga-Carvajal, E.T. Promotion of plant growth in arid zones by selected Trichoderma spp. strains with adaptation plasticity to alkaline pH. Biology 2022, 11, 1206. [Google Scholar] [CrossRef] [PubMed]
- López, C.G.; González, P.A.G. Selección de cepas nativas de Trichoderma spp. con actividad antagónica sobre Phytophthora capsici Leonian y promotoras de crecimiento en el cultivo de chile (Capsicum annuum L.). Rev. Mex. Fitopatol. 2004, 22, 117–124. [Google Scholar]
- Zhang, F.; Huo, Y.; Cobb, A.B.; Luo, G.; Zhou, J.; Yang, G.; Wilson, G.W.; Zhang, Y. Trichoderma biofertilizer links to altered soil chemistry, altered microbial communities, and improved grassland biomass. Front. Microbiol. 2018, 9, 848. [Google Scholar] [CrossRef]
- Baiyee, B.; Pornsuriya, C.; Ito, S.-I.; Sunpapao, A. Trichoderma spirale T76-1 displays biocontrol activity against leaf spot on lettuce (Lactuca sativa L.) caused by Corynespora cassiicola or Curvularia aeria. Biol. Control 2019, 129, 195–200. [Google Scholar] [CrossRef]
- Barnett, H.; Hunter, B. Illustrated Genera of Imperfect Fungi; Burgess Publishing Company: Minneapolis, MN, USA, 1972; p. 241. [Google Scholar]
- White, T.J.; Bruns, T.; Lee, S.; Taylor, J. Amplification and direct sequencing of fungal ribosomal RNA genes for phylogenetics. PCR Protoc. Guide Methods Appl. 1990, 18, 315–322. [Google Scholar]
- Zheng, H.; Qiao, M.; Lv, Y.; Du, X.; Zhang, K.-Q.; Yu, Z. New species of Trichoderma isolated as endophytes and saprobes from Southwest China. J. Fungi 2021, 7, 467. [Google Scholar] [CrossRef]
- Carbone, I.; Kohn, L.M. A method for designing primer sets for speciation studies in filamentous ascomycetes. Mycologia 1999, 91, 553–556. [Google Scholar] [CrossRef]
- Liu, Y.J.; Whelen, S.; Hall, B.D. Phylogenetic relationships among ascomycetes: Evidence from an RNA polymerse II subunit. Mol. Biol. Evol. 1999, 16, 1799–1808. [Google Scholar] [CrossRef]
- Staden, R.; Beal, K.F.; Bonfield, J.K. The staden package, 1998. In Bioinformatics Methods and Protocols; Springer: Berlin/Heidelberg, Germany, 1999; pp. 115–130. [Google Scholar]
- Kumar, S.; Stecher, G.; Tamura, K. MEGA7: Molecular evolutionary genetics analysis version 7.0 for bigger datasets. Mol. Biol. Evol. 2016, 33, 1870–1874. [Google Scholar] [CrossRef]
- Vaidya, G.; Lohman, D.J.; Meier, R. SequenceMatrix: Concatenation software for the fast assembly of multi-gene datasets with character set and codon information. Cladistics 2011, 27, 171–180. [Google Scholar] [CrossRef] [PubMed]
- Stamatakis, A. RAxML version 8: A tool for phylogenetic analysis and post-analysis of large phylogenies. Bioinformatics 2014, 30, 1312–1313. [Google Scholar] [CrossRef] [PubMed]
- Reyes-Tena, A.; Rodríguez-Alvarado, G.; Fernández-Pavía, S.P.; Pedraza-Santos, M.E.; Larsen, J.; Vázquez-Marrufo, G. Morphological characterization of Phytophthora capsici isolates from Jalisco and Michoacán, Mexico. Rev. Mex. Fitopatol. 2021, 39, 75–93. [Google Scholar] [CrossRef]
- Dennis, C.; Webster, J. Antagonistic properties of species-groups of Trichoderma: I. Production of non-volatile antibiotics. Trans. Br. Mycol. Soc. 1971, 57, 25–39. [Google Scholar] [CrossRef]
- Guigón-López, C.; Vargas-Albores, F.; Guerrero-Prieto, V.; Ruocco, M.; Lorito, M. Changes in Trichoderma asperellum enzyme expression during parasitism of the cotton root rot pathogen Phymatotrichopsis omnivora. Fungal Biol. 2015, 119, 264–273. [Google Scholar] [CrossRef]
- Anees, M.; Tronsmo, A.; Edel-Hermann, V.; Hjeljord, L.G.; Héraud, C.; Steinberg, C. Characterization of field isolates of Trichoderma antagonistic against Rhizoctonia solani. Fungal Biol. 2010, 114, 691–701. [Google Scholar] [CrossRef]
- Nascimento Brito, V.; Lana Alves, J.; Sírio Araújo, K.; de Souza Leite, T.; Borges de Queiroz, C.; Liparini Pereira, O.; de Queiroz, M.V. Endophytic Trichoderma species from rubber trees native to the Brazilian Amazon, including four new species. Front. Microbiol. 2023, 14, 1095199. [Google Scholar] [CrossRef]
- Cai, F.; Druzhinina, I.S. In honor of John Bissett: Authoritative guidelines on molecular identification of Trichoderma. Fungal Divers. 2021, 107, 1–69. [Google Scholar] [CrossRef]
- Dou, K.; Lu, Z.; Wu, Q.; Ni, M.; Yu, C.; Wang, M.; Li, Y.; Wang, X.; Xie, H.; Chen, J. MIST: A multilocus identification system for Trichoderma. Appl. Environ. Microbiol. 2020, 86, e01532-20. [Google Scholar] [CrossRef]
- Chaverri, P.; Branco-Rocha, F.; Jaklitsch, W.; Gazis, R.; Degenkolb, T.; Samuels, G.J. Systematics of the Trichoderma harzianum species complex and the re-identification of commercial biocontrol strains. Mycologia 2015, 107, 558–590. [Google Scholar] [CrossRef]
- Haouhach, S.; Karkachi, N.; Oguiba, B.; Sidaoui, A.; Chamorro, I.; Kihal, M.; Monte, E. Three new reports of Trichoderma in Algeria: T. atrobrunneum (South), T. longibrachiatum (South), and T. afroharzianum (Northwest). Microorganisms 2020, 8, 1455. [Google Scholar] [CrossRef] [PubMed]
- Philip, B.; Behiry, S.I.; Salem, M.Z.; Amer, M.A.; El-Samra, I.A.; Abdelkhalek, A.; Heflish, A. Trichoderma afroharzianum TRI07 metabolites inhibit Alternaria alternata growth and induce tomato defense-related enzymes. Sci. Rep. 2024, 14, 1874. [Google Scholar] [CrossRef] [PubMed]
- Pedrero-Méndez, A.; Insuasti, H.C.; Neagu, T.; Illescas, M.; Rubio, M.B.; Monte, E.; Hermosa, R. Why is the correct selection of Trichoderma strains important? The case of wheat endophytic strains of T. harzianum and T. simmonsii. J. Fungi 2021, 7, 1087. [Google Scholar] [CrossRef] [PubMed]
- Juan, Z.; Ting, L.; Liu, W.-C.; Zhang, D.-P.; Dan, D.; Wu, H.-L.; Zhang, T.-T.; Liu, D.-W. Transcriptomic insights into growth promotion effect of Trichoderma afroharzianum TM2-4 microbial agent on tomato plants. J. Integr. Agric. 2021, 20, 1266–1276. [Google Scholar]
- Inglis, P.W.; Mello, S.C.; Martins, I.; Silva, J.B.; Macêdo, K.; Sifuentes, D.N.; Valadares-Inglis, M.C. Trichoderma from Brazilian garlic and onion crop soils and description of two new species: Trichoderma azevedoi and Trichoderma peberdyi. PLoS ONE 2020, 15, e0228485. [Google Scholar] [CrossRef]
- Bedine Boat, M.A.; Sameza, M.L.; Iacomi, B.; Tchameni, S.N.; Boyom, F.F. Screening, identification and evaluation of Trichoderma spp. for biocontrol potential of common bean damping-off pathogens. Biocontrol Sci. Technol. 2020, 30, 228–242. [Google Scholar] [CrossRef]
- Redda, E.T.; Ma, J.; Mei, J.; Li, M.; Wu, B.; Jiang, X. Antagonistic potential of different isolates of Trichoderma against Fusarium oxysporum, Rhizoctonia solani, and Botrytis cinerea. Eur. J. Exp. Biol. 2018, 8, 1–8. [Google Scholar]
- Mokhtari, W.; Achouri, M.; Hassan, B.; Abdellah, R. Mycoparasitism of Trichoderma spp. Against Phytophthora capsici and Rhizoctonia solani. Int. J. Pure Appl. Biosci. 2018, 6, 14–19. [Google Scholar] [CrossRef]
- Anchivilca, P.I.T.; Vasquez, Y.F.; Borda, F.F.G.; Modeneci, G.R.L.; Quispe, K.L.H.; Melo, A.K.L.; Miranda, M.d.C.G. Antagonism of Native Trichoderma spp. from the Peruvian Central Rainforest on Phytophthora capsici and Effects on Capsicum annuum. Peruv. J. Agron. 2024, 8, 30–43. [Google Scholar] [CrossRef]
- Jambhulkar, P.P.; Singh, B.; Raja, M.; Ismaiel, A.; Lakshman, D.K.; Tomar, M.; Sharma, P. Genetic diversity and antagonistic properties of Trichoderma strains from the crop rhizospheres in southern Rajasthan, India. Sci. Rep. 2024, 14, 8610. [Google Scholar] [CrossRef]
- Yin, Y.; Tan, Q.; Wu, J.; Chen, T.; Yang, W.; She, Z.; Wang, B. The polyketides with antimicrobial activities from a mangrove endophytic fungus Trichoderma lentiforme ML-P8-2. Mar. Drugs 2023, 21, 566. [Google Scholar] [CrossRef] [PubMed]
- Yin, Y.; Zhu, G.; Wu, J.; She, Z.; Yuan, J.; Wang, B. Isolation of two peptaibols with potent antimicrobial and cytotoxic activities from the mangrove endophytic fungus Trichoderma lentiforme ML-P8-2. In Natural Product Research; Taylor & Francis: Abingdon-on-Thames, UK, 2024; pp. 1–6. [Google Scholar]
- Kraus, G.F.; Druzhinina, I.; Gams, W.; Bissett, J.; Zafari, D.; Szakacs, G.; Koptchinski, A.; Prillinger, H.R.; Zare, R.; Kubicek, C.P. Trichoderma brevicompactum sp. nov. Mycologia 2004, 96, 1059–1073. [Google Scholar] [CrossRef] [PubMed]
- Degenkolb, T.; Dieckmann, R.; Nielsen, K.F.; Gräfenhan, T.; Theis, C.; Zafari, D.; Chaverri, P.; Ismaiel, A.; Brückner, H.; Von Döhren, H. The Trichoderma brevicompactum clade: A separate lineage with new species, new peptaibiotics, and mycotoxins. Mycol. Prog. 2008, 7, 177–219. [Google Scholar] [CrossRef]
- Hammad, M.; Guillemette, T.; Alem, M.; Bastide, F.; Louanchi, M. First report of three species of Trichoderma isolated from the rhizosphere in Algeria and the high antagonistic effect of Trichoderma brevicompactum to control grey mould disease of tomato. Egypt. J. Biol. Pest Control 2021, 31, 85. [Google Scholar] [CrossRef]
- Sanabria-Velázquez, A.D.; Pavía, M.M.F.; Ayala, L.I.; Flores-Giubi, M.E.; Romero-Rodríguez, M.C.; Sotelo, P.H.; Barúa, J.E. Characterization of Trichoderma species from agricultural soils of Paraguay. Agron. Colomb. 2023, 41, e111299. [Google Scholar] [CrossRef]
- Tian, L.; Zhu, X.; Guo, Y.; Zhou, Q.; Wang, L.; Li, W. Antagonism of rhizosphere Trichoderma brevicompactum DTN19 against the pathogenic fungi causing corm rot in saffron (Crocus sativus L.) in vitro. Front. Microbiol. 2024, 15, 1454670. [Google Scholar] [CrossRef]
- Iswati, R.; Aini, L.Q.; Soemarno, S.; Abadi, A.L. Exploration and characterization of indigenous Trichoderma spp. as antagonist of Rhizoctonia solani and plant growth promoter of maize. Biodivers. J. Biol. Divers. 2024, 25. [Google Scholar] [CrossRef]
- Zhou, J.; Liang, J.; Zhang, X.; Wang, F.; Qu, Z.; Gao, T.; Yao, Y.; Luo, Y. Trichoderma brevicompactum 6311: Prevention and Control of Phytophthora capsici and Its Growth-Promoting Effect. J. Fungi 2025, 11, 105. [Google Scholar] [CrossRef]
- Khan, R.A.A.; Najeeb, S.; Hussain, S.; Xie, B.; Li, Y. Bioactive secondary metabolites from Trichoderma spp. against phytopathogenic fungi. Microorganisms 2020, 8, 817. [Google Scholar] [CrossRef]
- Malmierca, M.G.; Cardoza, R.E.; Alexander, N.J.; McCormick, S.P.; Collado, I.G.; Hermosa, R.; Monte, E.; Gutiérrez, S. Relevance of trichothecenes in fungal physiology: Disruption of tri5 in Trichoderma arundinaceum. Fungal Genet. Biol. 2013, 53, 22–33. [Google Scholar] [CrossRef]
- Cardoza, R.E.; Mayo-Prieto, S.; Martínez-Reyes, N.; McCormick, S.P.; Carro-Huerga, G.; Campelo, M.P.; Rodríguez-González, Á.; Lorenzana, A.; Proctor, R.H.; Casquero, P.A. Effects of trichothecene production by Trichoderma arundinaceum isolates from bean-field soils on the defense response, growth and development of bean plants (Phaseolus vulgaris). Front. Plant Sci. 2022, 13, 1005906. [Google Scholar] [CrossRef] [PubMed]
- Druzhinina, I.S.; Komoń-Zelazowska, M.; Ismaiel, A.; Jaklitsch, W.; Mullaw, T.; Samuels, G.J.; Kubicek, C.P. Molecular phylogeny and species delimitation in the section Longibrachiatum of Trichoderma. Fungal Genet. Biol. 2012, 49, 358–368. [Google Scholar] [CrossRef] [PubMed]
- Samuels, G.J.; Ismaiel, A.; Mulaw, T.B.; Szakacs, G.; Druzhinina, I.S.; Kubicek, C.P.; Jaklitsch, W.M. The Longibrachiatum Clade of Trichoderma: A revision with new species. Fungal Divers. 2012, 55, 77–108. [Google Scholar] [CrossRef] [PubMed]
- Anjum, N.; Shahid, A.; Iftikhar, S.; Mubeen, M.; Ahmad, M.H.; Jamil, Y.; Rehan, M.; Aziz, A.; Iqbal, S.; Abbas, A. Evaluations of Trichoderma isolates for biological control of Fusarium wilt of chili. Plant Cell Biotechnol. Mol. Biol. 2020, 21, 42. [Google Scholar]
- Sridharan, A.; Thankappan, S.; Karthikeyan, G.; Uthandi, S. Comprehensive profiling of the VOCs of Trichoderma longibrachiatum EF5 while interacting with Sclerotium rolfsii and Macrophomina phaseolina. Microbiol. Res. 2020, 236, 126436. [Google Scholar] [CrossRef]
- De la Cruz-Quiroz, R.; Roussos, S.; Rodríguez-Herrera, R.; Hernandez-Castillo, D.; Aguilar, C.N. Growth inhibition of Colletotrichum gloeosporioides and Phytophthora capsici by native Mexican Trichoderma strains. Karbala Int. J. Mod. Sci. 2018, 4, 237–243. [Google Scholar] [CrossRef]
- Lombardi, N.; Vitale, S.; Turrà, D.; Reverberi, M.; Fanelli, C.; Vinale, F.; Marra, R.; Ruocco, M.; Pascale, A.; d’Errico, G. Root exudates of stressed plants stimulate and attract Trichoderma soil fungi. Mol. Plant-Microbe Interact. 2018, 31, 982–994. [Google Scholar] [CrossRef]
- Silva, L.G.; Camargo, R.C.; Mascarin, G.M.; Nunes, P.S.d.O.; Dunlap, C.; Bettiol, W. Dual functionality of Trichoderma: Biocontrol of Sclerotinia sclerotiorum and biostimulant of cotton plants. Front. Plant Sci. 2022, 13, 983127. [Google Scholar] [CrossRef]
- Das, M.M.; Haridas, M.; Sabu, A. Biological control of black pepper and ginger pathogens, Fusarium oxysporum, Rhizoctonia solani and Phytophthora capsici, using Trichoderma spp. Biocatal. Agric. Biotechnol. 2019, 17, 177–183. [Google Scholar]

| Isolate | Municipality | Vegetal Species | Source | Species | ITS | TEF | RPB2 |
|---|---|---|---|---|---|---|---|
| 86CCS | Camargo | Capsicum annuum | Soil | Trichoderma afroharzianum | OR880629 | PP263668 | PP372571 |
| 87CCS | Camargo | C. annuum | Soil | T. afroharzianum | OR880630 | PP263669 | PP372572 |
| 88CCS | Camargo | C. annuum | Soil | T. afroharzianum | OR880631 | PP263670 | PP372573 |
| 57DPS | Delicias | Picea sp. | Soil | T. lentiforme | OR880621 | PP273408 | PP500715 |
| 58DPS | Delicias | Picea sp. | Soil | T. lentiforme | OR880622 | PP273409 | PP500716 |
| 63DPS | Delicias | Picea sp. | Soil | T. lentiforme | OR880623 | PP273410 | PP500717 |
| 70JES | Jiménez | Salsola Kali | Soil | T. longibrachiatum | OR880624 | PP273411 | PP526766 |
| 71JES | Jiménez | S. Kali | Soil | T. longibrachiatum | OR880625 | PP273412 | PP526767 |
| 73JCS | Jiménez | C. annuum | Soil | T. rifaii | OR880626 | PP273413 | PP500718 |
| 77JCR | Jiménez | C. annuum | Root | T. rifaii | OR880627 | PP273414 | PP500719 |
| 37MTS | Meoqui | Solanum elaeagnifolium Cav | Soil | T. arundinaceum | OR880618 | PP263665 | - |
| 40MCS | Meoqui | C. annuum | Soil | T. brevicompactum | OR880619 | PP263666 | PP393118 |
| 42MZR | Meoqui | Sorghum halepense (L.) Pers | Root | T. lentiforme | OR880620 | PP273407 | PP500714 |
| 17RCS | Rosales | C. annuum | Soil | T. afroharzianum | OR880613 | PP263660 | PP372568 |
| 19RCS | Rosales | C. annuum | Soil | T. brevicompactum | OR880614 | PP263661 | PP372569 |
| 24RQS | Rosales | Amaranthus sp. | Soil | T. afroharzianum | OR880615 | PP263662 | PP372570 |
| 27RCS | Rosales | C. annuum | Soil | T. brevicompactum | OR880616 | PP263663 | PP393116 |
| 10SQS | Saucillo | Amaranthus sp. | Soil | T. afroharzianum | OR880612 | PP263659 | PP372567 |
| 33SCS | Saucillo | C. annuum | Soil | T. afroharzianum | OR880617 | PP263664 | - |
| 85SCS | Saucillo | C. annuum | Soil | T. brevicompactum | OR880628 | PP263667 | PP393117 |
| Rhizoctonia solani | Phytophthora capsici | Fusarium sp. | ||||||||
|---|---|---|---|---|---|---|---|---|---|---|
| Species | Strain | Dual Culture | Non-VOC | VOC | Dual Culture | Non-VOC | VOC | Dual Culture | Non-VOC | VOC |
| T. afroharzianum | 10SQS | 39.367 abc | 19.747 bcd | 0 b | 74.2 abc | 47.157 de | 31.277 cd | 24.297 g | 45.713 fgh | 44.413 ab |
| T. afroharzianum | 17RCS | 59.56 ab | 52.627 abcd | 5.297 ab | 48.953 def | 82.847 ab | 58.677 a | 62.147 abc | 80.9 b | 52.627 ab |
| T. brevicompactum | 19RCS | 25.58 c | 42.237 abcd | 0 b | 60.523 abcde | 76.177 ab | 44.987 abc | 58.737 bc | 77.23 bc | 41.763 ab |
| T. afroharzianum | 24RQS | 39.97 abc | 41.763 ab | 0 b | 45.463 def | 37.98 efg | 41.92 abcd | 61.647 abc | 12.223 k | 38.517 ab |
| T. brevicompactum | 27RCS | 65.37 abc | 48.177 abc | 0 b | 43.03 ef | 34.143 efg | 30.613 cd | 54.92 cde | 48.57 bc | 48.177 ab |
| T. afroharzianum | 33SCS | 61.283 ab | 18.75 cd | 2.6 ab | 56.217 bcde | 84.02 ab | 52.397 abc | 63.957 ab | 28.757 ij | 19.747 b |
| T. arundinaceum | 37MTS | 41.86 abc | 56.223 bcd | 2.4 ab | 52.84 bcdef | 86.93 a | 3.853 e | 46.01 f | 75.653 bc | 22.017 b |
| T. brevicompactum | 40MCS | 51.077 abc | 48.247 bcd | 0 b | 43.913 ef | 86.93 a | 20.733 de | 54.317 cdef | 78.183 bc | 48.247 ab |
| T. lentiforme | 42MZR | 28.08 bc | 38.613 abcd | 1.25 ab | 44.66 ef | 28.613 g | 41.387 abcd | 49.537 def | 51.7 efg | 38.613 ab |
| T. lentiforme | 57DPS | 28.593 bc | 60.273 a | 9.187 ab | 47.477 def | 26.383 g | 46.86 abc | 56.727 bcd | 22.72 jk | 58.64 a |
| T. lentiforme | 58DPS | 29.027 bc | 58.64 a | 4.623 ab | 58.003 abcde | 70.54 bc | 51.757 abc | 58.633 bc | 35.51 hi | 55.423 a |
| T. lentiforme | 63DPS | 34.543 abc | 39.16 a | 14.9 ab | 51.507 cdef | 58.943 cd | 54.46 ab | 60.34 abc | 42.337 gh | 60.273 a |
| T. longibrachiatum | 70JES | 20.153 c | 46.83 abcd | 6.37 ab | 46.55 def | 58.913 cd | 39.067 abcd | 48.997 def | 71.933 cd | 46.83 ab |
| T. longibrachiatum | 71JES | 48.313 abc | 35.04 abcd | 7.797 ab | 56.283 bcde | 36.077 efg | 45.857 abc | 47.193 ef | 60.963 de | 35.04 ab |
| T. rifaii | 73JES | 18.69 c | 47.25 abcd | 0 b | 53.427 bcdef | 43.207 ef | 46.967 abc | 48.593 def | 100 a | 47.25 ab |
| T. rifaii | 77JCR | 35.14 abc | 48.79 abc | 7.737 ab | 43.04 ef | 28.4 g | 55.523 ab | 49.597 def | 25.06 ij | 48.79 ab |
| T. brevicompactum | 85SQS | 41.677 abc | 14.773 d | 0.933 b | 29.143 f | 86.93 a | 35.173 bcd | 68.977 a | 84.353 b | 46.997 ab |
| T. afroharzianum | 86CCS | 29.373 bc | 37.523 abcd | 0 b | 76.587 ab | 31.553 fg | 47.35 abc | 54.117 cdef | 51.897 efg | 37.523 ab |
| T. afroharzianum | 87CCS | 40.98 abc | 43.797 abcd | 0 b | 81.72 a | 32.153 fg | 55.42 ab | 55.12 cde | 57.54 def | 43.797 ab |
| T. afroharzianum | 88CCS | 24.03 c | 36.057 abcd | 9.403 ab | 69.397 abcd | 29.103 fg | 56.333 ab | 56.63 bcd | 47.237 fgh | 36.057 ab |
Disclaimer/Publisher’s Note: The statements, opinions and data contained in all publications are solely those of the individual author(s) and contributor(s) and not of MDPI and/or the editor(s). MDPI and/or the editor(s) disclaim responsibility for any injury to people or property resulting from any ideas, methods, instructions or products referred to in the content. |
© 2025 by the authors. Licensee MDPI, Basel, Switzerland. This article is an open access article distributed under the terms and conditions of the Creative Commons Attribution (CC BY) license (https://creativecommons.org/licenses/by/4.0/).
Share and Cite
Rodríguez-Martínez, E.S.; Rios-Velasco, C.; Sepúlveda-Ahumada, D.R.; Buenrostro-Figueroa, J.J.; Correia, K.C.; Guigón-López, C.; Alvarado-González, M. Trichoderma Species from Semiarid Regions and Their Antagonism Against the Microorganisms That Cause Pepper Wilt. J. Fungi 2025, 11, 174. https://doi.org/10.3390/jof11030174
Rodríguez-Martínez ES, Rios-Velasco C, Sepúlveda-Ahumada DR, Buenrostro-Figueroa JJ, Correia KC, Guigón-López C, Alvarado-González M. Trichoderma Species from Semiarid Regions and Their Antagonism Against the Microorganisms That Cause Pepper Wilt. Journal of Fungi. 2025; 11(3):174. https://doi.org/10.3390/jof11030174
Chicago/Turabian StyleRodríguez-Martínez, Erika Sireni, Claudio Rios-Velasco, David Roberto Sepúlveda-Ahumada, José Juan Buenrostro-Figueroa, Kamila C. Correia, César Guigón-López, and Mónica Alvarado-González. 2025. "Trichoderma Species from Semiarid Regions and Their Antagonism Against the Microorganisms That Cause Pepper Wilt" Journal of Fungi 11, no. 3: 174. https://doi.org/10.3390/jof11030174
APA StyleRodríguez-Martínez, E. S., Rios-Velasco, C., Sepúlveda-Ahumada, D. R., Buenrostro-Figueroa, J. J., Correia, K. C., Guigón-López, C., & Alvarado-González, M. (2025). Trichoderma Species from Semiarid Regions and Their Antagonism Against the Microorganisms That Cause Pepper Wilt. Journal of Fungi, 11(3), 174. https://doi.org/10.3390/jof11030174

